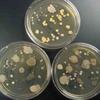

| ||||
Science Image Library
Bacterial Colonies & Streak Plates
1. Obtaining arm plate sample of normal flora on skin; 2. Normal flora bacterial sample from an arm plate; 3. Close up of normal flora bacterial colonies from arm plate sample; 4 & 5. Touch plates, far shot & near. Tpo plate is unwashed hands, bottom left, washed, bottom right scrubbed soap & alcohol.
Bacillus subtilis
bacterial colonies grown on TSY agar. These bacteria hare heavily flagellated, so can move. See how colonies spread out in lobes.
1. Micrococcus luteus colonies growing on TSY agar; 2. Streak plate of M. luteus colonies growing on TSY agar, 3, 4 & 5. Arm plate of normal flora of skin. Creamy yellow round colonies are Micrococcus.
Staphylococcus Bacterial Colonies on TSY
(Click on photo to enlarge.) See more >
Micrococcus luteus Bacterial Colonies on TSY
(Click on photo to enlarge.)
Arm Plate & Touch Plate Bacterial Samples
(Click on photo to enlarge.)
Science Image Library: Bacterial Colony Photos
Page last updated: 8/2015
SCIENCE PHOTOS
SPO VIRTUAL CLASSROOMS
 | ||||||
SCIENCE VIDEOS
The Microbiology Photo Image Library is the largest photo collection on the SPO site. To help you more easily find what you are looking for, select the "see more" link of the sub-topic below that corresponds to your interests or use the "Search" box.
The SPO Science Image Library is a continuously growing collection of copyright- free science photographs. If you use one of our free, low-res images, we just ask that you give us credit and provide a link to the SPO website (scienceprofonline.com). Click on a photo to enlarge it. To save a photo to your computer, right click on it and select "Save".
 | ||||||
HOME MICROBIOLOGY EXPERIMENT FROM SPO
TSY agar with sample from dirty dishes on top (note bacterial colonies that grew), and sample from cleaned dishes on bottom.
Colonies of Gram Positive Bacteria
Bacillus subtilis Bacterial Colonies on TSY
Continued ... Go to PAGE 2 >
See Page 2 for more photos of bacterial colonoes, including Mycobacteria and Gram-negative bacteria!
Upper left: Plate of Staphylococcus epidermiis colonies written as S. epi, and growing on TSY agar; Upper right: Streak plate of S. epidermidis
viewed from bottom;
Left: Punctiform, creamy white Staphylococcus bacterial colonies on TSY.
For those in need of high-resolution images, we will soon be offering hi-res files of many photos in the Science Image Library. Follow us on Facebook to get updates on new SPO features and products. If you need a high resolution photo now, please contact us.
You have free access to a large collection of materials used in a college-level introductory microbiology course. The Virtual Microbiology Classroom provides a wide range of free educational resources including PowerPoint Lectures, Study Guides, Review Questions and Practice Test Questions.
The SPO website is best viewed in Microsoft Explorer, Google Chrome or Apple Safari.
This page features colonies of epidermal normal flora bacteria and bacterial colony morphology of mainly Gram positive species.
Gram-negative bacterial colonies growing on MacConkey's agar. A pink colony indicates that the bacteria eat the sugar lactose.